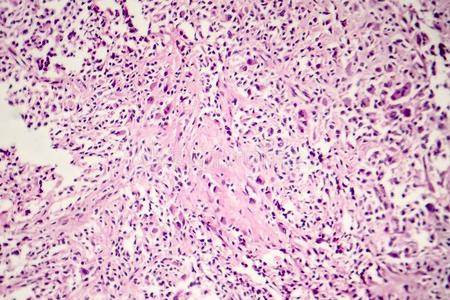
身体肉芽肿化脓性肉芽肿在眼试验红细胞背景上有毒性肉芽的中性粒细胞

肿胀红细胞

这是种血细胞病,正常的血红细胞是像甜甜圈一样的扁平圆形,而镰状细胞
图片尺寸640x426
细胞水肿-延安大学医学院病理学
图片尺寸999x868
红细胞检查
图片尺寸140x108
白细胞增加,血红蛋白减少,红细胞计数减少.
图片尺寸660x371
切开排脓(四)出血性炎炎症病灶的血管损伤严重,渗出物含大量红细胞
图片尺寸768x576
红细胞呈钱串状
图片尺寸220x168
主要由于新生儿肝脏代谢胆红素的能力较弱,红细胞破坏较多,肠肝循环
图片尺寸1080x1440
肉芽组织,肝细胞脂肪变,慢性肝淤血,慢性肺淤血,混合血栓,肝脓肿,各种
图片尺寸1536x2048
今天血象都很低 输升白细胞针 输红细胞 输血小板 还发烧 脸也
图片尺寸1080x1439
2 mg/l,红细胞沉降率为10.
图片尺寸902x811
红细胞高渗图片
图片尺寸400x300
巨噬细胞吞噬淋巴细胞,红细胞和细菌碎片之后形成伤寒细胞3.
图片尺寸1071x608
五种症状赶紧去医院|白血病|白细胞|淋巴结|骨髓|儿童|癌症|-健康界
图片尺寸830x608
身体肉芽肿化脓性肉芽肿在眼试验红细胞背景上有毒性肉芽的中性粒细胞
图片尺寸450x300
低于血浆渗透压的溶液为低渗溶液,可造成红细胞的肿胀而发生溶血
图片尺寸553x290
脾脏肿胀等反应,其中有心内膜炎,felty综合症等,还包括球形红细胞增多
图片尺寸500x375
切换新版 >> 不再显示 × 图1下图:小箭头标识的为影红细胞,大箭头
图片尺寸1281x961
红细胞是红色的吗?
图片尺寸536x217
其吞噬能力十分活跃,胞浆中常吞噬有伤寒杆菌,受损的淋巴细胞,红细胞
图片尺寸245x304
(4)核变性:中性粒细胞肿胀性变化是指胞体肿大,结构模糊,边缘不清晰
图片尺寸1080x860